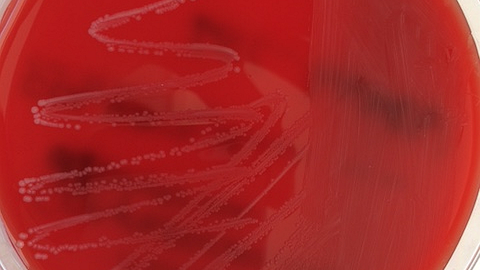
Petrischale mit rotem Nährboden zeigt einen Belag mit Erregern

Unlängst wurde die Bakterienart aber weiter aufgegliedert und zwei neue Spezies beschrieben: C. belfantii und C. rouxii. Unser Labor hat gerade eine Fallserie publiziert, bei welcher insgesamt drei Fälle von C. rouxii-Infektionen bei Hunden in Deutschland nachgewiesen wurden, die wegen Hautveränderungen in Behandlung waren. Die Bakterien wurden biochemisch und mittels Flugzeit-Massenspektrometrie (MALDI-TOF MS) zunächst als C. diphtheriae identifiziert. Mit Hilfe der Ganzgenomsequenzierung gelang die genauere Differenzierung. Bei der Arbeit waren weitere Labore der Universitäten Gießen und München sowie das Konsiliarlabor für toxigene Corynebakterien beteiligt. Die Hunde litten unter chronischen nässenden bis eitrigen Hautentzündungen oder großflächigen, schweren Verletzungen.
Nachweis innerhalb von 24 Stunden
Alle Tupferproben wurden kulturell-bakteriologisch auf Nährböden ausgestrichen. Nach 24 Stunden Inkubation bei 37° C konnten die Erreger (neben bakterieller Begleit-Mikrobiota) nachgewiesen werden. Es folgte eine Differenzierung mit Hilfe von biochemischen Verfahren und der MALDI-TOF-Massenspektrometrie. Zusätzlich wurden alle drei Isolate auf Ihre Antibiotikaempfindlichkeit mittels Mikrobouillondilution geprüft. Eingehende molekularbiologische Untersuchungen wie verschiedene Polymerase-Kettenreaktionen (PCR) sowie eine Ganzgenomsequenzierung der Isolate durch das Konsiliarlabor rundeten das diagnostische Spektrum ab und ergaben keine Hinweise auf Diphtherie-auslösende Toxine. Allerdings stufen wir diese Bakterien auch nicht als harmlos ein, denn nahe verwandte Bakterien werden regelmäßig zwischen Menschen und ihren Haus- und Heimtieren bei engem Kontakt übertragen. Auch Wildtiere können C. rouxii beherbergen, wie der Nachweis bei einem Fuchs beweist (Sing et al. 2016). Vertreter dieser Gruppe sollten daher genau überprüft und bis auf Speziesebene ausdifferenziert werden. Denn aufgrund der wenigen weltweit nachgewiesenen Fälle und Krankheitsverläufe ist davon auszugehen, dass es sich auch bei C. rouxii um einen Zoonoseerreger handelt. Leider lagen bei unseren Fällen in keinem Fall Proben der Tierbesitzer vor, um diese Hypothese untermauern zu können.